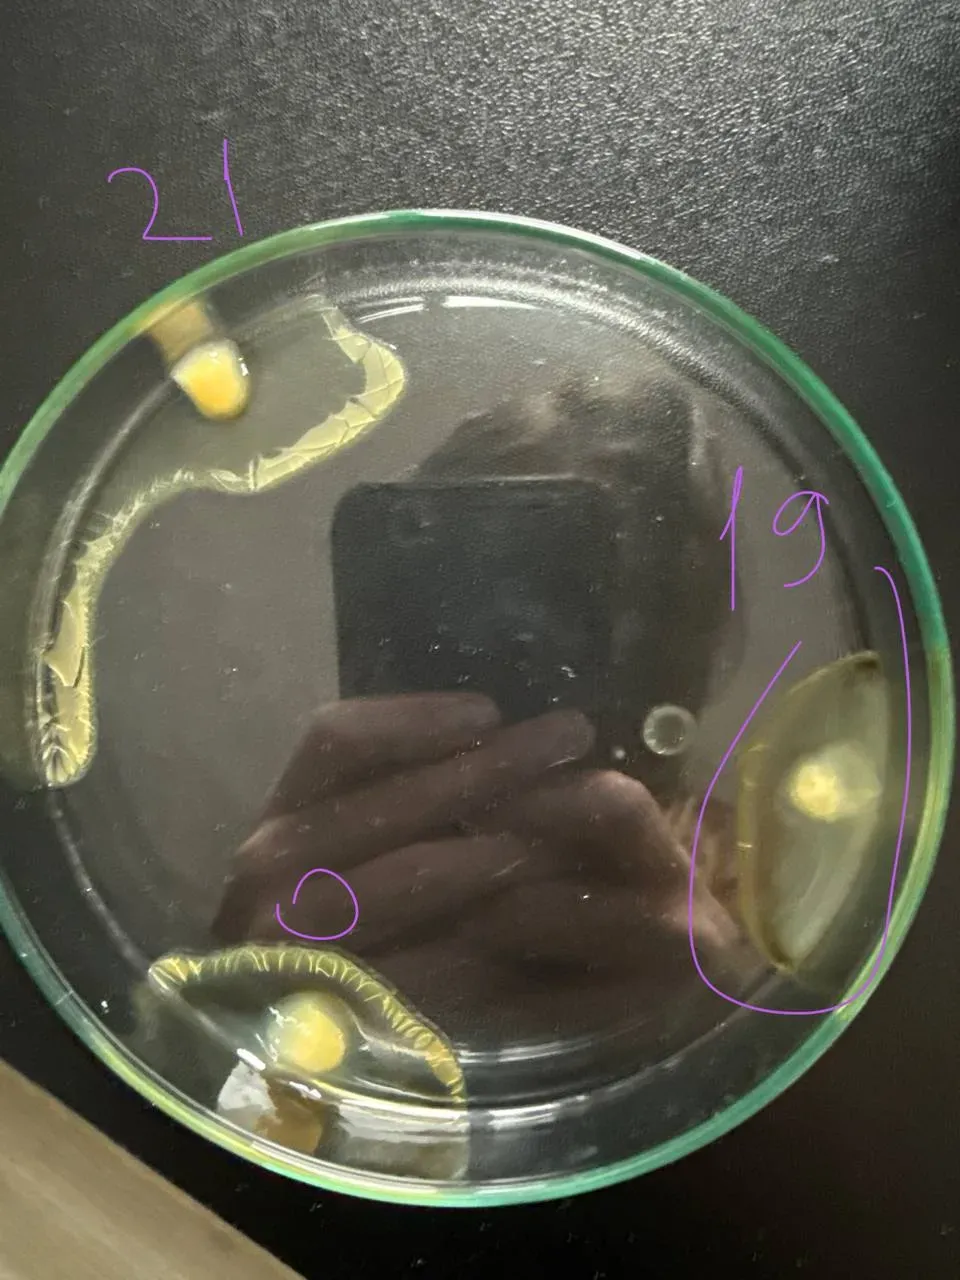
Blood plasma flask sample

Blood Plasma Study
Статистически значимое воздействие гиперболического поля на коагуляцию плазмы крови, подтверждённое на 7 пациентах с p = 0.027.
Кто мы?
ASRP LLP — исследовательская организация со штаб-квартирой в Байконуре, Казахстан, специализирующаяся на технологиях гиперболического поля и их биологических приложениях. Исследование проведено совместно с Олесей Чирковой из SASU Point Rouge (Франция). Основная команда: Денис Банченко (CEO), Валерия Овсянникова (CBO), Михаил Капустин (CTO).Наша миссия
Наша миссия — выяснить, способно ли нехимическое полевое воздействие существенно влиять на фундаментальные биологические процессы, такие как свёртывание крови. Демонстрируя воспроизводимую, статистически значимую модуляцию динамики коагуляции, мы стремимся заложить основу нового класса нефармакологического контроля свёртывания. Исследование зарегистрировано на OSF (osf.io/8q42f, DOI: 10.17605/OSF.IO/GWA9E).
Цель проекта
Цель — получить воспроизводимые, рецензируемые доказательства того, что воздействие гиперболического поля модулирует коагуляцию крови канально-специфичным образом. Критерий успеха — достижение статистической значимости (целевое p < 0.05) на нескольких пациентах и формирование доказательной базы для будущих клинических применений в области нефармакологического контроля свёртывания.
Ключевые результаты
Канал 19 — ускоренный жизненный цикл:
Описание:
Канал 19 вызвал повышенное образование сгустков (71–78% образцов) по сравнению с контролем (62–65%). Среднее количество сгустков — 8.92, площадь сгустков — 0.90%. Образцы вели себя так, будто «постарели» — ускоренный цикл коагуляции указывает на то, что поле Канала 19 ускоряет естественные процессы свёртывания. Случаев лизиса не зафиксировано.

Канал 21 — замедленная коагуляция:
Описание:
Канал 21 снизил частоту образования сгустков до 41–54% против 62–65% в контроле. Среднее количество сгустков — 5.64 (−37%), площадь — 0.52% (−42%). Это единственный канал, зафиксировавший случай лизиса — растворения сгустков. Образцы выглядели биологически «моложе», что свидетельствует о замедлении коагуляционного каскада. Текстурный контраст (GLCM) повышен на 28%.

Применения и интеллектуальная собственность:
Описание:
Возможность ускорять или замедлять коагуляцию без медикаментов открывает перспективы в лечении ран, оптимизации хранения крови, предоперационной подготовке и создании новых антикоагуляционных терапий. Технология защищена патентом KZ 2025/1095.1 (Фрактальная биомедицинская система), зарегистрированным 14.03.2025.

Методология исследования
Методология исследования
- Забор крови (4 пробирки от каждого донора)
- Центрифугирование (2000 об/мин, 5 минут)
- Разделение плазмы по каналам воздействия
- Облучение гиперболическим полем (~1 ч 12 мин на пациента)
- Покадровая 4K съёмка (1 кадр каждые 5 мин, 24–48 ч)
- ИИ/ML анализ (8 моделей: Gemini, Claude, GPT, DINOv2 и др.)
- Статистическая обработка (ANOVA, t-тесты)
7 доноров, 101 фото, 40+ одноканальных образцов. Формат ID образца: канал.пациент.номер. Шкала коагуляции: none → early_fibrin → partial_clot → full_coagulation → lysis. Температура среды: постоянная 17°C.

Статистическая значимость
Множество архитектур ИИ показывают 46–58% точности классификации каналов против 33% случайного угадывания — это указывает на воспроизводимый сигнал, а не на случайность.
- Gemini 2.5 Flash: точность 57.9%, p = 0.027 (статистически значимо)
- DINOv2: 47.4%, p = 0.15
- GPT-5 / Perplexity: ~46.7–53.3% (согласованные результаты)

Патент и OSF-регистрация
Fractal Biomedical System
Технология, используемая в исследовании плазмы крови, защищена патентом на Фрактальную биомедицинскую систему гиперболических полей. Исследование зарегистрировано на Open Science Framework (OSF Preregistration), что обеспечивает полную прозрачность и воспроизводимость результатов.
OSF: osf.io/8q42f — Исследование зарегистрировано на Open Science Framework

Связанные исследования
Исследование плазмы крови связано с другими проектами ASRP через общие технологии гиперболических полей и методы мультиконвейерного анализа.

Галерея исследования
Результаты покадровой 4K съёмки образцов плазмы крови: пробирки, колбы и микроскопические снимки процесса коагуляции.

Команда исследования
Исследование проведено междисциплинарной командой специалистов в области биоинженерии, ИИ и физики полей.



Свяжитесь с нашей командой
Отправьте нам сообщение, чтобы начать разговор

